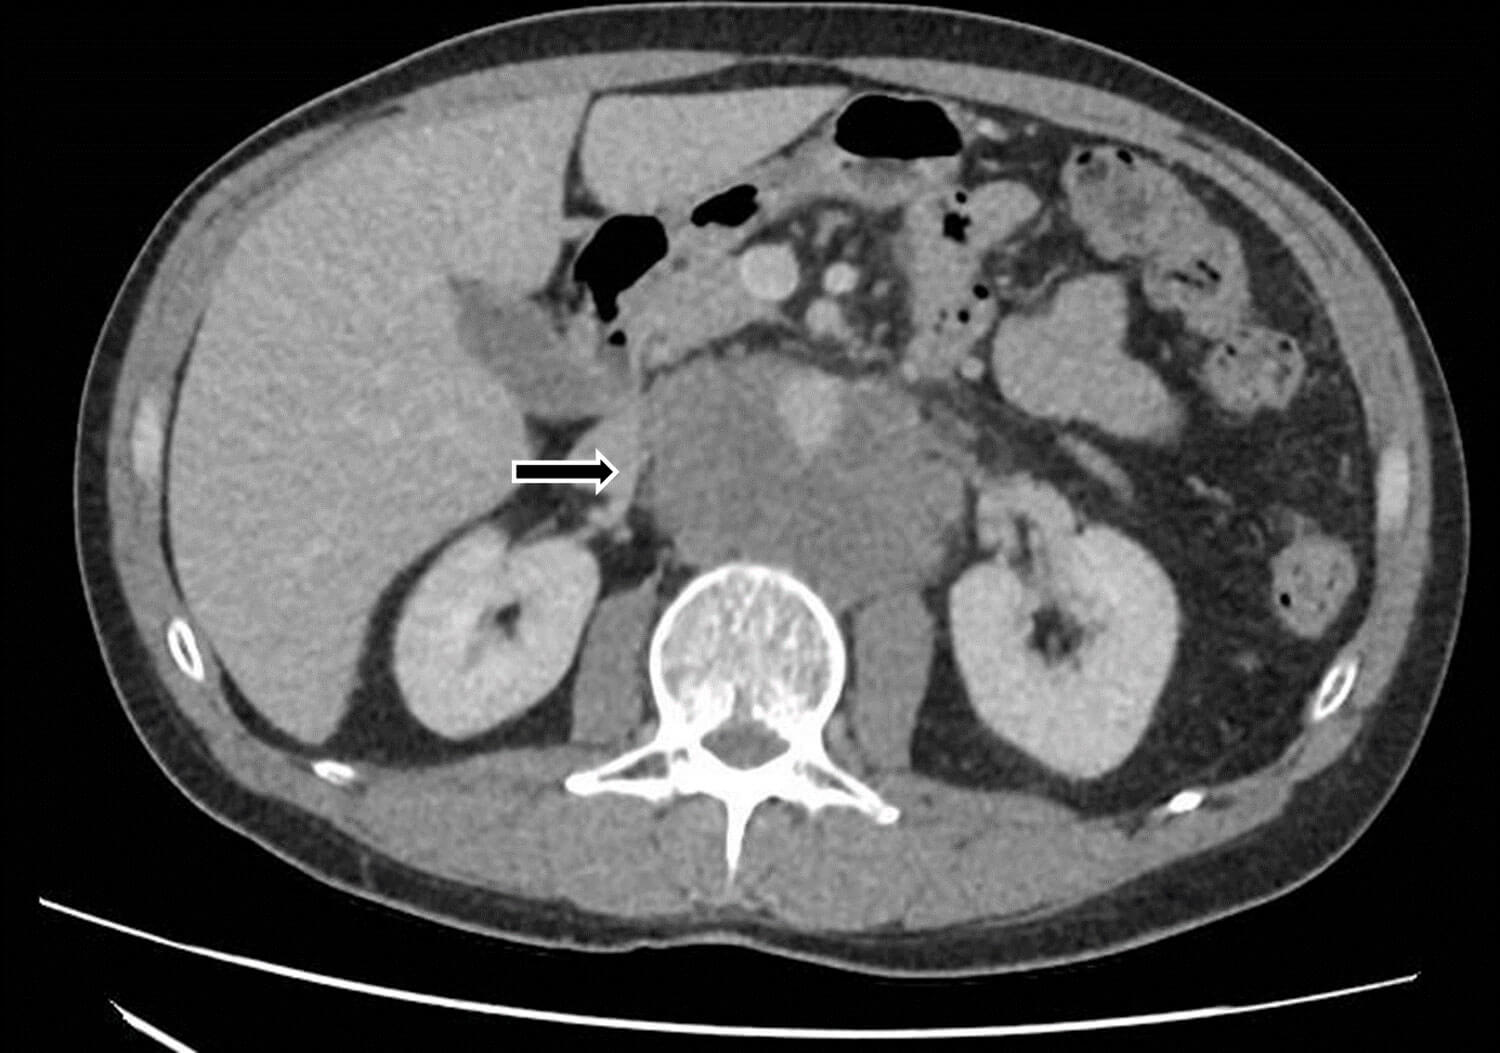

Most testicular cancers present with a painless lump on the testes, and most are confidently diagnosed on examination and ultrasound. They have an excellent prognosis, with 90% patients alive at 10 years [1]. However, advanced testicular cancer, or those with unusual presentations, can be more challenging to diagnose.
Anecdotally, these presentations seemed to increase during and immediately after the COVID-19 pandemic. We share four such cases at our trust, with our own learning points, which we hope will help other urologists in future cases.
CASE 1: Abdominal and back pain
A 43-year-old man attended his GP with a three month history of worsening abdominal and back pain. An ultrasound (US) of the abdomen showed prominent para-aortic lymph nodes and he was referred under the two-week-wait for suspected cancer of unknown primary. A CT abdomen and pelvis demonstrated a large conglomerate retroperitoneal mass, suspicious for lymphoma, as well as a large pulmonary embolus (Figure 1).
Figure 1: Large retroperitoneal mass extending to the common iliac vessels.
The patient was commenced on low molecular weight heparin and a CT-guided biopsy was performed - histology showed metastatic seminoma, and he was referred to the urology team. A subsequent US testes showed a 1.5cm right sided testicular lesion (Figure 2).

Figure 2: Lesion on the testicular midpole undersurface, with reduced reflectivity, classical for seminoma.
Radical inguinal orchidectomy was performed the next month, which showed fibrosis and atrophy only. The patient completed four cycles of ifosfamide, epirubicin and cisplatin chemotherapy whilst as an inpatient. He had an excellent response and remains under surveillance with the oncology team.
Learning points
-
Always consider the possibility of primary testicular malignancy with retroperitoneal masses.
-
Thorough clinical examination is essential for all cases of cancer of unknown primary.
-
Testicular tumours can regress, resulting in atrophic and fibrotic histology.
-
Close liaison with haematology is important when thromboembolic disease is present with metastatic disease.
CASE 2: Bilateral testicular tumours
A 25-year-old man was referred by his GP with an enlarging right testicular swelling and discomfort starting after minor trauma. He had a background of previous brain pineal germinoma, metastatic to the distal cervical cord and cauda equina, which had been fully treated and was in remission. He also had a family history of testicular cancer.
On examination, the right testicle was globally irregular, with the left atrophic and difficult to examine. US of the testes showed a grossly abnormal right testicle, measuring 92 x 53 x 60mm, and two small lesions with vascularity in the upper pole of the left testis concerning for malignancy (Figure 3).

Figure 3: Two abnormal areas on the left atrophic testis arrowed (L) and grossly abnormal right testicle (R).
Tumour markers were elevated, and a staging CT showed enlarged pathological retroperitoneal lymph nodes. After detailed counselling regarding either staged or partial orchidectomy with multiple healthcare professionals, the patient requested bilateral radical orchidectomies, which were performed one month post diagnosis and after sperm banking. The right testis histology showed a pT2 mixed germ cell tumour (embryonal 30%, yolk sac 35%, teratoma 35%), and the left testis demonstrated pure seminoma, pT1. He recovered well and completed one adjuvant cycle of bleomycin, etoposide and cisplatin (BEP). He remains disease free at the time of reporting.
Learning points
-
Bilateral testicular tumours are rare but are recognised.
-
The balance of oncological with functional outcome should always be discussed with patients in such cases.
-
The need for multidisciplinary teams (MDT) is of paramount importance - involvement with oncology, endocrinology, embryology, genetic counselling and Macmillan CNS teams can help best inform patients prior to treatment.• Consider specialist regional MDT if necessary.
CASE 3: Chest pain
A 23-year-old man presented to A&E with sudden onset chest pain, hypotension and tachycardia. A chest x-ray was suggestive of a mass posterior to the heart, and a bedside echocardiogram was suspicious for an atrial mass measuring 6 x 6cm. The patient was reviewed by both the cardiology and respiratory teams. A CT and MRI thorax showed a large mediastinal mass compressing the left atrium, but the aetiology was inconclusive with differentials including a benign bronchogenic cyst (Figure 4). Imaging surveillance was recommended and the patient was discharged home.

Figure 4: 7 x 5 x 7cm low attenuation mediastinal mass compressing the left atrium.
He represented five months later when he collapsed at home with seizures and a reduced Glasgow Coma Scale (GCS). On further questioning, he reported headaches for the past 11 weeks and poor vision from his left eye. An MRI brain showed a haemorrhagic lesion in the occipital lobe and multiple ring-enhancing lesions in the cerebrum and cerebellum suspicious for brain metastases (Figure 5).

Figure 5: Haemorrhagic lesion in the right occipital lobe and ring enhancing lesion in the cerebellum, suspicious for metastases.
A repeat CT chest, abdomen and pelvis redemonstrated the large mediastinal mass, unchanged in size, but with new mediastinal lymphadenopathy and bilateral pulmonary metastases. Lymph node biopsy concluded choriocarcinoma as final histology. Testicular examination and ultrasound were highly suspicious for right testicular malignancy. The patient was urgently transferred to a specialist trophoblastic disease centre for inpatient chemotherapy.
Unfortunately, he died shortly after commencing treatment due to a cerebral bleed.
Learning points
-
Atypical masses in the mediastinum or retroperitoneum in men - think testicular cancer.
-
Choriocarcinomas are highly aggressive but usually respond well to chemotherapy - earlier detection can permit lifesaving chemotherapy.
-
There are three National screening and treatment centres for trophoblastic disease in the UK:
- Charing Cross Hospital Trophoblast Disease Service, London.
- Sheffield Trophoblastic DiseaseCentre, Weston Park Hospital, Sheffield.
- Scottish Hydatidiform Mole Follow-up Service, Ninewells Hospital, Dundee.
CASE 4: Referral to urology for hydronephrosis
A 51-year-old man presented to A&E with symptoms of lethargy, weight loss, decreased appetite and abdominal pain for one month. He had been treated for prostatitis with antibiotics by his GP without improvement in symptoms. He was examined by the medical team and consultant who found no testicular abnormality. His chest x-ray showed cannonball metastases, and a CT found a large retroperitoneal mass encasing the pulmonary vein, right hydronephrosis, liver metastases and subcarinal lymph nodes (Figure 6).

Figure 6: Large retroperitoneal mass encasing the great vessels.
A biopsy of the liver was organised and the patient referred to urology for management of the hydronephrosis. US testes was requested on urological advice which showed a multiloculated cystic mass containing thick internal septations and internal vascularity, typical for choriocarcinoma (Figure 7). Liver biopsy confirmed the diagnosis and subsequent β-HCG was found raised at 225,383mIU/mL. The patient was transferred urgently to a specialist centre for inpatient chemotherapy. He responded well and treatment is ongoing.

Figure 7: Multiloculated cystic mass of right testicle containing thick internal septations and demonstrating internal vascularity.
Learning points
-
When clinical suspicion is high, testicular examination should be performed by an experienced clinician.
-
There should be a low threshold for testicular ultrasound due to its sensitivity.
-
Serum tumour markers are an essential component in the diagnosis and work up of such cases.
-
A urinary β-HCG pregnancy test can be helpful as a bedside test to facilitate a rapid diagnosis of testicular cancer in time-critical situations [2].
References
1. Cancer Research UK. Survival for testicular cancer.
https://www.cancerresearchuk.org/about-cancer/
testicular-cancer/survival
[Last accessed February 2025]
2. Paramore L, Chetwood AS. Role of urinary pregnancy testing in the diagnosis of men with testicular cancer. Ann R Coll Surg Engl 2025;107(1):73.
Declaration of competing interests: None declared.







